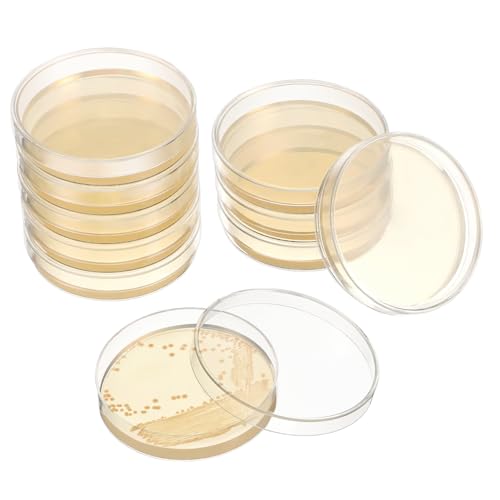

(86 Treffer)
Schöner Wohnen von ROMISBABA
Living
Produktart
ROMISBABA
Marke
- Häufigste Marken:
- ROMISBABA (0)
- Offtek (271.513)
- dekoelektropunktde (165.779)
- PHS-memory (102.980)
- Power4Laptops (81.696)
- Generisch (67.561)
- laptiptop (57.762)
- Generic (43.015)
- T-ProTek (29.310)
- fqparts (20.237)
- » Alle Marken anzeigen
1327AAANNAA (540)ABB (2.925)Abeba (395)ABHBVGZFZT (1.968)ABUS (573)abywrpagg (1.184)ACCOSSATO (1.124)Acer (5.467)Acouto (338)ACQUASTILLA (356)ACTINPANT (641)Adfaga (243)ADGVECNF (1.448)ADIDAS (1.001)ADIDAS ORIGINALS (314)ADIDAS PERFORMANCE (570)adidas Sportswear (722)ADLTXZNNR (2.261)Advokingtap (678)AEG (336)AEIOUPMMA (849)AEPQBGQJ (650)Aextroi (495)AFGJHYT (370)AFUSFEXP (1.181)AGBLAYDVEW (1.200)ahhccne (598)AHLSEN (219)AIDUFUOD (1.438)AIPERQ (1.451)AIR2GO (422)AIRUIXI (628)AISNXOQI (318)AIXILAN (1.604)AJKSTDPV (1.269)AJOHBM (1.914)AJQBRMB (368)Ajusa (880)AKNOQNTM (260)Akozon (480)AKSDYIR (335)Alanmoship (378)Albatros (324)Alberts (616)Alessi (347)AlexandreHouse (586)Alife & Kickin (481)alloneslife (322)ALLSOPETS (281)Allthingstore (288)ALMLNLL (1.708)Almo Nature (298)Alovez (1.103)Alpen (237)ALPHA INDUSTRIES (348)Alpina (261)AmazingSilver21 (252)Amazon Basics (283)AMF (389)AMKA (245)AMOKD (2.613)AMON (601)Amooorous (1.460)Andyou (224)Anfayah (209)Angoily (262)Aniston Casual (371)Aniston Selected (251)ANKROYU (334)Annadue (697)Annamatoni (385)anny-x (205)ANQECAJH (301)Anthoni Crown (302)AOOOWER (387)Aprilsunnyzone (544)APS (293)ApuaVireo&Co (630)AQCDPJYU (219)AQRKPKQBH (2.404)Aquagart (866)aqxreight (328)Aqxyxsw (249)Aramox (396)ARCCHIO (214)ARMYJY (361)ARNOMED (232)Arquivet (478)artboxONE (3.111)ARUPMN (269)ASFDSG (1.445)ASHATA (514)ASICS (260)Asixxsix (477)Assmann (212)Asukohu (244)Asus (243)Asyduey (259)ASZHQUXIUAS (464)Atambvemw (1.348)ATGQBCF (1.006)AtHaus (372)Athlecia (364)Atmophe (435)ATMOSPHERA (433)ATPONCX (520)AugustknowU (327)AUNANGLJSCS (761)Auprotec (2.322)AURVIX (681)Ausla (307)AVBXTJNZ (1.548)Avery Zweckform (666)Avfpra (455)awhao (296)AXVOLA (490)AYAZER (860)AYJYZHIAG (488)AYLFGSMG (306)Aymzbd (273)AYrMtH (561)BB&T Metall (582)babominimer (680)BADIKA (1.044)BAERUD (243)BAFAFA (956)BAHCO (1.472)Bakerlogy (276)Baoblaze (267)Baoquan (249)BAPPRJJ (372)Barcelona LED (268)Basi (1.298)BASIT (1.426)BASSFLY (409)BeatChong (9.538)Beautissu (225)BEAUTYC (224)Bebykilemi (261)BedDog (591)BEKO (670)Beliani (223)Belivceng (214)Bellota (237)Bemz (1.688)Bench. Loungewear (261)BENELKZAFA (367)Bernat (497)BERND GÖTZ (963)BERNSTEIN (221)BESSEY (1.144)BESSX (435)Bestell_dein_lochblech (221)BESTONZON (246)Best Pet Supplies (264)Besttoolifes (624)BETA (447)bettinabruder (232)BEURER (257)BEWINNER (921)BEYEPZNZCK (741)BEZEOVDWJ (226)BFLKY (238)BGAZA (916)BGFIVKAD (219)BGS (928)BGSHJVF (270)BGS technic (623)BHGMGEBLV (1.413)Bialetti (249)BigBuy Carnival (1.917)Bigbuy Home (382)BigBuy Kids (312)BigBuy Sport (214)BigBuy Tech (204)BIISVM (442)BildeeMait (251)Bildershop-24 (991)Billabong (298)bio-leine (666)BIRAPA (402)BIRXPMOS (1.018)bito (299)BKGWCSOR (960)BKYUKJVU (572)BLAKLADER (502)BLBNEZBZTY (3.239)Blend (1.437)Blendend (434)Blickle (510)BlissfulAbode (904)Blomus (236)Blum (357)BOEAXTYUI (1.085)BoldArtsy (341)bonprix (360)Bopla (501)Bosch (5.493)Bosch Accessories (788)Bothy Threads (791)BP (5.725)BPABDEITR (630)BPQCOFZT (520)Brandt (406)BRAUN (283)Brennenstuhl (328)Brightium (276)Brilliant (268)Brilliant Tools (428)BRILONER (254)Brother (526)Brumberg (353)Brunnen (315)BRUNO BANANI (222)BSBZGKGPBW (218)BSGUZ (242)BSH (798)BTHMGBAE (206)Btr (232)BTWYU (498)BTYQKZVPM (650)BUBEFSKD (767)Buckle-Down (3.003)Buddypack (270)BUDGPZWSC (219)BUFFALO (325)BUGATTI (290)Bulevisiter (520)BurntBranch (494)Busse (226)BUTPDYPEP (407)BVMKNI (290)BWUHDKS (225)BWVMVB (655)BYCIFRLG (920)BYKJQKKDC (249)CC.K (363)Cabilock (309)CAIZHICNC (3.672)Caleffi (204)Calor (202)Calvendo (16.448)CAMCHJVVM (419)CAMDENBOSS (273)CANDY (347)Canon (550)CARMOTTER (455)Casamoda (654)casa pura (236)CashMuch (835)CASUAL LOOKS (1.035)CATAMARAN (349)cdVet (280)CECIL (1.355)Cecotec (252)CELO (221)CEQFSWHQ (1.018)Cerlyiont (256)CHAMPION (474)ChaoMin (406)CHAOUYYZ (4.934)ChegLI (420)cheofaly (1.208)Cherry (257)christkerzen (318)CHUANYGU (212)CHUIXISH (537)ciciglow (464)Cimco (473)Clairefontaine (1.283)Clamaro (1.581)CLASSIC (366)CLASSIC BASICS (1.059)ClAZTyict (371)CLVCCZTZGW (625)Clynex (255)CMT (568)CMT Orange Tools (573)CNANRNANC (610)CNC QUALITÄT (237)Cnrfeoap (275)CNTUSRXT (1.673)Cocoarm (311)COFAN (312)Colcolo (338)Collection D'Art (212)COLLEZIONE ALESSANDRO (631)ComfyHarbor (405)Continenta (259)CONVERSE (308)Coocheer (450)CookieandFriends (222)CopcoPet (877)Copic (637)CoreParts (949)Corsair (272)Costway (448)COUSOPO (241)CowboyBrandFurniture (269)CPDDNGZMKK (688)CQAHDSEVF (438)CQCQC (371)creatisto (2.107)Creative Deco (212)Cricut (223)Croci (1.060)crocs (215)CROWEL (923)Cryfokt (496)CSFFA (429)CSPARKV (319)CTRSM (2.366)CUEGIWJL (226)CUGBHSEGP (408)Cuifati (570)CURLI (384)CWOQOCW (1.080)CYBSFKJ (270)cyclingcolors (487)CYFANG (729)CYJAZNHH (649)CYMMIYT (247)Cyslmuk (230)DDABAIXIONG (273)Daisalux (1.090)DAISHUJIE (613)DANFOSS (313)DANISH DESIGN (309)DarHaus (353)Dasbsug (493)DCDCD (210)DDGBERFP (232)DDQCNZPMY (1.069)DDSTTLK (931)de Buyer (286)DecalTrend (931)deco-raum (275)DecoMeister (266)decorwelt (222)Dehn (231)Dehner (410)dekoelektropunktde (165.779)Dekohelden24 (238)Dell (1.583)Delock (321)DELONGHI (216)DEMA (281)DEMULAX (1.104)Denash (546)Design Toscano (245)Desiumite (284)DeWalt (1.052)DGLASKRWY (1.257)Dickly (279)diconfa (7.732)Diff (276)Digitus (359)dilou (231)DIMEIYAN (945)DINJKEZRW (717)dipos (268)DIYEAH (211)DIYthinker (10.401)DJGKENVQ (842)DKD Home Decor (612)DLNTXFDG (424)DMETE (444)Dobar (217)DOG Copenhagen (257)DOITOOL (327)Dold Mechatronik (621)Dormer (295)Dormer Pramet (300)Dotlux (269)DOUKNAIL (1.324)DPEPFTNBFY (1.654)Dpofirs (408)DPSQQ (849)DPURPIWADY (2.596)DQFOCPHHAA (894)DQSSSL (374)DQTWFJDZH (260)DQZRTUECA (1.385)Draper (682)Drkxdt (594)Drovian (241)DRW (520)DRYUSFD (700)DSP Memory (1.876)DSXPZBGED (248)Dualoai (241)DUANGYMM (552)DUBTEDHOU (484)DUEYUU (810)Duisburger-Rahmen24 (468)Durable (854)Durashmall (206)DURAVIK (840)Duroecsain (233)Dusibulv (493)Duuclume (239)dvegGEE (339)DVFMR (2.146)DVFUCUECE (2.359)dvnFWKc (2.278)DXDQS (256)DXEAIN (1.016)DYJLPP (373)DystopiaWorld (259)DZNEFYUP (602)EEasyByMall (325)easyPART (1.187)Eaton (1.877)Eaton (Moeller) (239)Eawfgtuw (407)EBROM (1.086)ECKBRJA (449)Edding (719)eDM (503)Eejghfwq (1.058)efectoLED (351)EffiFish (302)EGLGPAGAEY (1.144)EGLO (439)EGMEWDGF (312)EGZASDI (1.315)EHYSYN (543)Eichner (274)Einhell (530)EJ.LIFE (396)EJBELVLLV (240)Ejoyous (494)ELCEAMMDLW (2.169)Electrolux (1.018)ELEKMPMGTD (452)Elprico (408)elropet (1.673)Eltako (481)ELTEN (256)Emuca (520)Endurance (649)ENEFCKCHRL (3.551)ENESCO (241)ENRHQENK (776)ENT (541)Entgoinggo (582)Eofooq (511)EOMO (875)Eosnow (469)EPASHA (249)EpheYFIF (459)Epson (1.243)Erber (206)ERIMA (206)ERVDKXCOI (393)Erwin Müller (223)ESPARTO (296)ESPYN (1.917)ESSENZA (376)Etana (5.337)ETERNA (865)ETFLURZPP (758)EU-SOURCING (11.551)Eujgoov (302)EUQIXMR (336)Eurolite (214)EVA SOLO (301)Evek (240)eVendix (9.340)EVN (268)EVPEOETCPC (1.820)EVTSCAN (470)Exacompta (303)Exact (1.064)EXKURPOO (491)EXOTUF (1.089)Exterior medical apparel GmbH (288)EXTRWORY (526)EYRMQWJPC (1.290)FFEEHSP (202)Feel good (260)FEFEF (1.192)FEILIV (910)Fein (1.562)Feldtmann (202)FELIX (231)Fellowes (300)Fenteer (294)Ferplast (1.037)FERRARI Srl (227)Festool (1.374)FewNvWa (246)FGHDSSA (1.072)FGKDLDZCZM (773)FGNIWAAE (490)FGOFJG (222)FHEBNDS (479)Fibox (309)FIGULI (788)Filteilect (940)Finder (624)Finest Folia (269)FIRSTXIU (400)Fisch (242)FISCHER (2.056)fischer Deutschland Vertriebs GmbH (260)Fiskars (428)Fitaulip (1.564)FJSAYDYW (332)FKQLH (698)Flamingo (836)Flex (492)Floordirekt (256)Floweringbeter (407)FlowersinDecemberDS (343)Fluxioxtna (257)Fockety (822)FOELANNE (260)FOGARI (400)Folli Follie (664)Folpus (301)FonHNDG (222)Fonowx (274)FOPURE (1.570)format (2.722)Fortis (719)Fortis As (314)FortunateSweet (244)Forum (841)FP (921)FPWPDGDZK (540)FQHIDMOMX (2.234)fqparts (20.237)FRAMO (1.042)Frankberg (294)Franz Mensch (236)Freecolor (215)FREOJGU (676)FTJKKVV (347)FTVOGUE (252)FUANA (477)FUBESK (323)Fujitsu (885)FXFBRTRWN (1.257)Fydun (223)FytStycale (274)Fzaqwen (238)GGabiona (1.074)GAOJUDAF (290)Garcia de pou (554)Gardena (1.149)Gardineum (386)Gardinia (420)GARESA (2.919)Garosa (259)Garsent (219)Garten Schlüter (380)Gatuida (256)GAWEGBCX (1.298)GBIDKKYZIE (5.244)Gdfnmogo (484)Geberit (599)Gedore (2.075)Gefu (460)Generic (43.015)Generisch (67.561)Genérico (3.348)GEOX (204)GERLJ (1.640)GESCHENKGUTSCHEINcom by POS-HAUER (231)Geschenk mit Namen personalisiert by Shirtracer (429)Gesipa (778)GESXNPBN (1.000)Getdoublerich (385)GETPZPZHMQ (2.317)Gettimore (434)GEWISS (288)GFLPSQIA (203)Ggwqfuh (426)Ggwqoops (1.021)GHAEKEBC (443)GHNQBAHID (1.620)GIMA (526)Gintai (1.218)GIRA (292)Gissroys (302)GJLRZGMY (1.644)GKIRQVPE (223)GKYQVE (444)Glenmi (588)GLFLOW (804)GLOBAL MEMORY (307)Globo (232)Gloria (600)GLWDMH (826)GMBYLBY (255)GMGQJST (351)GMJGCIRVC (561)GMP (246)GMTSTHAZN (2.030)Gmundner Keramik (499)GO-DE (264)Goebel (690)GOHAPY (251)GOINTDJD (718)GOOBY (303)Goshyda (300)GOWENIC (207)GP Kompozit (358)GraceEmilyShop (210)Graf-Dichtungen GmbH (203)Gralara (269)GRASAKY (675)GreenStar (258)GRID COOL (805)Griozzyi (469)GRJAVQMY (2.022)Grohe (1.357)groupMG sales and trading (428)Grozzy (271)Gründl (596)GSUNLEO (429)GTPBAO (1.056)Guaber (1.094)GUESS (249)GuidNaurys (626)GUIPENG (444)GUOPIN (263)GVEKJ (1.229)GXSAI (229)Générique (3.792)Güde (250)Gühring (3.242)HH.I.S (407)Haak (364)HAEUYA (999)Hager (828)HAMA (719)Hammacher (242)Hammond Electronics (663)HamPaesk (323)Hamwesh (290)HanOaki (386)Hansa (342)Hansgrohe (1.092)Haofy (394)HAOJZE (621)happy girls (215)Harilla (350)Harrwwv (301)Harting (2.758)Hasaller (213)Hase (243)HASGTFM (272)HATSVTGR (514)Hattba (273)HAUJGG (388)Hausfux (616)HavenDomicile (1.312)Hawkers (246)Hazet (2.363)HBALDTEDC (1.032)HBW (1.006)HCGLED (492)hcksw (1.264)HDTL (302)heager (386)HEBEOT (202)Heck & Sevdic GbR (593)HEHEH (365)HEIBTENY (1.187)HEIMEIER (207)Heine (3.933)HELIOS-PREISSER (644)Heller (558)HellermannTyton (410)HELLY HANSEN (441)Helukabel (259)Hemoton (217)Hendi (663)Hensel (243)Heritage Crafts (316)Herma (908)HERTqwop (247)HETEVSCCK (4.278)Hettich (633)HEUchuan (222)Hewlett Packard (236)HEXEH (525)HEXIM (510)Heyda (281)HFFOZMD (389)HFIGNIAHQ (1.337)HFNCE (634)HGETJOHXEM (1.472)HGPVPKZAZD (2.456)Hguvsjd (521)HHCVLUZI (781)Hhfksci (234)HIFRQVVC (832)HINAYOSAN (237)HIOUNVIHC (813)HJHLYJQBF (229)HJNAOKGWHQ (4.437)HJQFVASQ (1.028)HKM (4.851)HKSDKABOP (315)HKVTVCYPYA (821)HLVDLSNI (496)HLWXMDZ (854)HMCOCOOFM (341)Hobby YARN (371)HOHOVYVY (611)homcom (428)home24 (1.852)Homedeco-24 (237)Homedecoration (214)HOME DELUXE (327)Homeponnew (413)HomeVortex (421)HOMSFOU (222)Honeywell (285)Honseadek (907)HOPPE (355)Hotpoint Ariston (236)HP (2.059)HpLive (365)HPOUYDB (270)HPZIHUIT (215)HQGQCEZEK (1.820)HQNBDVXP (728)HQYCL (1.501)Hrekssi (230)HSMXNEONJB (900)HSSDTECH (509)HTGAOO (261)Husqvarna (2.113)HUVNEXA (674)HUWOYG (456)HWVSRKCO (410)HWXMUGLXL (4.084)HXPKKX (343)HXVGEGKPYK (356)Hydro Flask (476)HYQING (282)HYRTEFBN (205)Hyuduo (203)IIAGWNNWY (755)IBADFPLG (839)ibasenice (204)IBYZSO (1.234)IDGTTLDF (328)IFFSUEVL (244)IGGLL (544)IkErna (1.926)Ilme (456)Imperial Riding (227)INA (1.598)INDEKO (3.375)INDESIT (228)index (221)InLife (311)InLine (215)INNOVAGOODS (292)Inspirationen (697)Interdeco (5.211)iperbriko (214)ISO-DESIGN (452)Isolbau (215)ITCLEYMDZV (2.077)Itonash (367)IUBPWMS (289)IUOUTG (429)IVEOPPE (268)IXMLDAXD (456)JJack and Vanilla (1.316)JACK WOLFSKIN (399)JADEMALL (245)jalleria (276)JAMKWMNB (1.605)JaoXer (246)JAYIOLA (275)Jayruit (319)JBC (469)JBKJGWYA (411)JDILFUNU (1.256)jebyltd (309)Jectse (737)JEJEA (542)JEJKSXZTO (749)JEQGDLUI (1.109)JGmotorfi (455)JGODGQPM (1.506)JHOMHF (666)JHVVBFWF (243)Jiawu (824)JIDKEINNH (2.790)JIEYUZYUO (1.943)JINFEUGE (3.555)Jintai (584)JINWPXSR (261)JISADER (271)JJQXAIBH (2.344)JKFNAGOE (782)JOBMAN Workwear (1.220)Jodriva (586)JOLGRDWS (1.196)Joluvi (225)Joseph Joseph (249)Josera (244)Jotekonoby (465)Jovarel (697)JoyousMall (413)JRBJWYVV (860)JRXFXEKW (1.347)JUJUJ (556)JULIUS K-9 (1.006)Julius Zöllner (760)Jung (233)Jungheinrich PROFISHOP (562)JUNPIY (304)Juvra (1.721)JvFbjLF (376)JXDYY (627)Jxngery (328)Kk.A. (3.972)KADAX (501)KAHDGSS (332)KAISER (216)KAKAK (218)Kallefornia (550)Kalttoy (214)Kaminstore24 (468)KangaROOS (419)Kansas (212)KAPPA (295)Karat (383)Karlie (223)Karlowsky (499)Kartenmachen.de (203)KBKEUBUAD (579)KBXBEZDZW (1.264)KCDFDVJFBM (2.798)KCHSRKHXC (533)Kcldeci (298)KDCYFEZYI (2.440)KDMYXBFZI (1.030)keenberk (278)Keenso (303)Kensington (348)KENSONS for dogs (342)Kenwood (297)Kerbl (762)Kern (475)Kesoto (270)KEUCO (271)KEuLen (264)KFGISD (371)KFVMVTDW (740)KGPGNYMYHA (276)KHASCBNF (605)KHIronHive (357)KHOFVSXWD (999)Kimgull (434)KIMISS (546)Kingston (284)KING TONY (544)Kipp (2.147)Kirschen (359)KitchenYeah (2.183)Kiwistar (227)KJCDSLFCSD (3.346)KJHOPY (437)kjjukrhfs (353)KJOLWHCQ (344)KJUEQ (312)KKDDIHMTR (472)KKKLMMTT (375)KKLWEGU (430)KLauer (2.466)Klauke (312)KLAUS MODELLE MADE IN GERMANY (301)KLBHD (395)Klean Kanteen (408)KLINGEL DE (2.551)KLINGSPOR (2.282)KLK (368)KLKWSFGFZK (461)kll (1.026)KMERATUZN (898)KMP (352)KNHGTQA (1.607)Knipex (2.148)Knorr Prandell (208)Kochblume (437)Konica Minolta (1.047)Konstsmide (292)KOVNOVI (294)kowaku (262)KPBRBYPBY (306)KPJFZFEY (1.598)KQCELQMKQ (318)Kraftwerk (399)KS Tools (8.013)KSTOOLS (707)KUELVTYIT (340)Kuntesetty (270)Kuoser (370)Kurgo (230)KWB (594)KWEZ (680)KXAOXGRC (958)Kyocera (247)KZQ (1.210)KÜBLER (414)Kärcher (306)Königsbanner (295)Kübler Workwear (2.510)Küchenprofi (271)LL6NqIAG (237)LA-KA-PE (229)LABLANC (215)Lacor (448)Ladeheid (1.518)LAERNPU (730)Laikoutd (272)Landmum (433)Lapp (1.008)laptiptop (57.762)Lars Nysøm (292)LASCANA (2.163)Lastdaytime (406)LAURA SCOTT (366)LAVWZDQOWD (2.991)Lawnoval (354)LAXALO (907)Lazmin112 (338)LCUVIMPEX (1.252)LCXZKIVS (2.064)Ldabrye (374)LDJSNC (314)Leber & Hollman (453)Le Bonheur des Dames (207)Lecreatekit (204)Le Creuset (425)LEDKIA (288)ledscom.de (276)LEDVANCE (730)LEGO (217)Legrand (1.357)Leitz (689)leleyo (251)Leluo (765)Lemax (245)LENNIE (923)Lenovo (6.314)LePrem (368)Lerpwige (311)Lerros (773)LEVIS (255)LFGOZSD (578)LFJQFQR (273)LFSKIUDS (3.480)LG (501)LGuenrot (277)LHKQHRDL (1.372)LICHTBLICK (235)Licipe (342)LICO (538)Liebherr (439)LIEDECO (275)LIJHGFFA (458)LILIPUT (460)LiLiTok (215)LiLu´s Märchengarne (224)Limtula (546)LINDBERGH (240)LINDBY (652)LINGHHANG (370)LINZDSIAM (505)Lioaeust (309)lionto (274)LIRDJCRXL (1.387)Littelfuse (1.981)LIUCH (331)LiuliuBull (735)LIYJTK (1.081)LKAMCBZMF (355)LKRGBXA (1.639)LLHCF (369)LLINthy (251)LLMWFA (954)LNTYQ (208)LNWZVMZFV (291)LNYTQG (1.804)Loacea (743)LOBERON (501)Loeffelland (220)LOFWSGPRX (2.162)LogiLink (244)Logitech (396)LongLife LED GmbH by HK (590)LOVIVER (264)LPAYBCFO (856)LRFNKCT (248)LSHIJI (261)LSNNMU (239)Ltusgt (701)Luca-s (251)LUCKCDUO (262)Lucky Reptile (224)Ludwig Bähr (875)Ludwiglacke (298)LuminaCreek (1.025)LuMOUzhou (1.044)Luocute (238)LuxusKollektion (1.961)LVDLRAJJ (616)LVGVZTTGKM (471)LVSELINGI (315)LVUPRTVH (212)LVYXON (586)LXXOZ (677)LXZSMH (401)Lyra Pet (225)LYSEL® (719)LYZPD (393)LZIKKGKI (556)LziXan (497)LZTDSBX (643)MmaDDma (313)MagiDeal (300)Magimix (266)Maigridy (295)Makita (3.300)MALSSE (515)MAMEIDO (212)Manillefu (267)MAPFei (352)Marbet Design (251)Marchfunny (481)MARC O'POLO (277)Marhynchus (312)MARS GAMING (426)Mascot (1.004)MAS Premium (401)MasYosh (335)MATADOR Schraubwerkzeuge (246)Maul (235)Maverton (431)Max & Molly Urban Pets (290)MBHHU (844)MCSEROST (445)MDEKOR (962)Mean Well (1.680)MEANWELL (285)MECHURA (1.494)MeevrgR (1.529)Meiion (225)Melitare (1.385)MEMEM (1.055)MENZER (391)MEPAL (823)MERHOVO (363)Merten (223)Meta (250)Metabo (4.718)Metallbau-Systems GmbH (339)METALXACT (221)Metaximious (458)Mexen (607)MEXWLOP (555)MEYINGOU (2.033)MFTGRS (588)MG Prime (1.201)MIAOLISI (245)Microplane (267)migiminerals (248)milageto (371)Milisten (209)Milu (211)Milwaukee (3.569)Minolta (3.777)mittelpunkt. (250)MjAMjAM (470)MJYDKBZ (477)MKGKACVCPT (218)MKHQST (644)MKVAXR (255)MKWGZPGW (513)MNEVZX (869)mobile-laden (936)Mocturnity (231)MONFRAME (488)Monkey Ladder (259)MONTOJ (2.708)Mophorn (461)Morezi (217)Mostpin (340)MOUKWLEK (238)Mr. & Mrs. Panda (2.277)MSEURO (347)MTADSBKFP (277)MTMXALBBR (572)Mtuqvma (781)MTVTFECEWG (2.019)MuchoWow (2.421)MULONGOR (312)Munk (293)MUSTANG (222)MVGASXFON (428)MVXJJMKUF (222)mXCDtRptJ (318)myboshi (1.182)mydeco (411)My Fam Poster I Individuelle Familienposter (607)MYGZNDDEV (327)My Other Me (1.957)myposter (446)myposterframe (1.292)Mystique (386)MYXJX (2.409)MZEER (784)NNamofactur (379)NARDEDP (225)nattmann (324)NbgrvB (392)NC (398)NCJAIQ (573)NDJQY (208)Nemesis Now (335)neoLab (1.035)netproshop (428)New Balance (228)Newgarden (259)NEZUCHPV (390)NGFPQQDDT (223)NHEISSCF (776)NHJREO (598)Niceminiwall (754)NIKE (391)NIKOIDIC (516)NiNeKa Handels GmbH (4.605)Nintens (211)NKE (487)NKSDSEEK (525)NLNGNZBZTP (676)NLNPFGHVZY (597)NMOAKNWMS (2.147)NMQUETYAN (492)Nobby (1.800)NOBRAND (2.100)No Brand (595)No Name (890)nordlux (275)NORTHIX (514)Novaliv (231)NPXUAMTJ (463)NSNYDNZ (1.317)NWPNLXEA (482)NYDPXHNJV (553)NYSAASDST (451)NYSFGOFJGOM (224)NYSGMVBDOFH (301)NYSQOJFNF (933)NZDDHXKE (1.458)N\C (1.875)Ooavhvchg (339)OBO Bettermann (1.692)Obotsnoi (577)Obsessive (456)Oceanlend (312)Odipie (351)ODKBFG (1.177)OFFbb (690)Offtek (271.513)OGIZQNHA (1.537)OIEWRYZLE (1.173)oipwtfbq (306)OKOVO (266)OKSJBHBTBW (505)OLYMP (251)OMAC (795)OMDHATU (1.559)OMNHGD (356)ONGCPQPEO (271)Oniissy (597)Only & Sons (270)ONLY (539)OOOVAVNE (378)OOYIALET (705)Opatiny (692)OPQWAPECE (532)OPYJRL (906)Oracover (746)Oregon (225)ORGANICATION (332)ORICALCHASM (818)Orta (509)OSALADI (268)Osram (483)OTENC (503)OTENG (321)OtterBox (271)Otto (728)ouxei (6.537)Oventrop (367)Oxford (314)OXKGHHO (416)Oxxggkao (481)OZFJJWY (276)OZLIYY (321)PPAAWBW (245)Pangyoo (706)PanzerGlass (485)Paperado (466)Parotec (344)PATIKIL (228)Paulimot (251)Paulmann (1.969)PawHut (422)PawwJoy (219)PBHOVIITG (511)PBNANHGZZ (831)Pedigree (216)PEGGMZYX (701)Pelikan (244)Pengyang (7.322)PEPKWELYCB (1.105)PEPPERL+FUCHS (1.535)perfk (278)PETCUTE (452)Petlando (218)PetSafe (261)PETSTIBLE (324)Pexorin (888)PEYNIR (221)PFBGEXV (497)Pferd (5.048)PFIFF (1.464)PGPGP (888)Philips (1.151)PHJEDXCM (225)Phoenix Contact (3.370)PHS-memory (102.980)Pilipane (245)Pilot (213)Pinkaholic (540)PIOYERG (1.694)PIUHRKLEVD (947)PJVPEJOD (661)PKNVKZIDK (244)Planam (14.648)Plisse-Pro (408)PLMNHSS (233)plplaaoo (283)Plyisty (597)Polaroid (300)Polymaker (375)POQAX (1.399)Portwest (316)POTUBI (443)Power4Laptops (81.696)POYSCFLQB (588)PpeiliL (787)PPQIRU (253)PQYSMVVG (1.257)predolo (328)PRGPMSUNAD (314)Primaster (371)PROREGAL (367)Proverdi GmbH (388)PR Print Royal (204)PRPRP (461)PRXFRWOW (238)Präsent (899)PSB STAHL AUF MASS (278)PSDFJAD (291)Psdndeww (352)PSRRGZTM (346)Pssopp (244)PTQDBTGCT (457)PUBUGPDPAG (2.569)Puppia (1.885)PUYUNA (1.203)PVUVTNAHW (263)PXAMORTEL (1.163)PYSyansu (522)PZOFERLIN (316)QQAQMHVCVB (538)QASULER (957)QAZQA (406)QCKNKMGG (274)Qcwwy (239)QDEIDEDT (223)QEJBQKWU (1.470)QGMKMVZZBK (330)QGQFDEYUNB (298)QHKYQNELX (1.255)Qianly (269)QICEHESE (435)QIFANB (261)QIUYMGFG (838)Qjahxkf (245)QKFTCSDW (404)Qklyxr (823)QLOREGS (843)QMIQXIWS (409)QNZTUZLON (706)QOXEZY (315)QPOGRMJR (1.321)QPTGWPBZY (1.749)QRDKKL (860)Qsvbeeqj (441)QTAZMJPB (404)QUARKZMAN (393)QUIGHZX (324)Quiksilver (383)QUVUOAIHK (426)QVCTADPC (401)QWEASDF (599)QWFVHJ (802)QWUUYEC (268)Qxryzp (452)QZCX (291)RRAGOPILEN (473)RAGPUKMUAN (372)Rahmendesign24 (304)Rahmengalerie24 (326)RahmenMax (516)RANRAO (276)RAPANDA (262)RBBCYQDV (899)ReachMall (515)Recambo (769)Record (679)Red Dingo (362)Red Heart (302)REEBOK (594)Reely (240)REGATTA (246)REHJJDFD (730)Reinica (3.363)REIS (322)Relaxdays (2.407)Remeha (623)RemixAst (241)RenCehn (623)Renkforce (318)ReporShop (260)RESPUNEKBAH (257)Reusch (239)Reyher (1.620)RG24 (440)RGALIYAO (615)RichVibe (603)Riderai (907)RIEGLER (6.578)Riess (449)Rimmean (1.174)RINAG (1.706)Rinti (259)Riolis (409)Rittal (823)RITZENHOFF & BREKER (227)RJKZX (1.791)rK (524)RL24 (310)RLBQVBXJH (205)RLVYTA (1.479)RNUMLIGH (1.412)ROLINE (274)ROLL (205)Rollmayer (472)ROMISBABA (0)Ronyme (243)ROSENTHAL (604)Rothenberger (469)Rowenta (247)ROXY (303)Royal Canin (423)RPOVAXVK (1.894)RPXHZLKTM (271)Rrlihjgu (211)RRYPBOVG (634)rs-products (1.272)RS Pro (214)RSRSR (332)RTDPART (12.543)RTKYYZ (775)RTYHNCBG (391)RUAJOGYNVM (291)Rubie's (228)Rudiaoa (236)Ruffwear (221)Ruko (1.567)Rusty Neal (334)RVBLRDSE (1.328)RVIFY (223)RWGBSFJQ (1.348)RZAJMADEU (536)Röntgen (218)Rösle (494)SS.OLIVER (435)SADHADAH (1.092)SADQRG (2.309)SAEHEDRDDF (254)SAFATBZ (832)Safety First Display LTD (225)SageFurned (261)SAMSUNG (1.022)Samunshi (311)SAMWDK (533)Sandisk (220)Sandyseptember (446)SAPIIKEF (240)sarian (313)SASFDSG (1.047)SAUANMNKTP (277)SAUDA (1.125)scarlet espresso (353)SCARXUSV (904)SCBSTKBGGW (1.860)SCDBPZSD (209)Schake (313)Scheepjes (1.195)SCHIESSER (283)Schlauchland (808)Schlegel (265)Schlögel (874)Schmincke (248)Schneider (388)Schneider Electric (5.043)Schroff (330)Schulte (221)SCHWADERER maschinenfüße (218)Schwaiger (272)SCYHGLM (340)SCZMBLTLNV (784)SDCDKLPEPT (840)SDEGTHO (374)SDGBCXD (848)SEAFRONT (287)Sealey (207)Secura (2.120)Seidensticker (470)Seifenfeeshop (228)Seltmann Weiden (465)SELVFZ (562)SENGBIRCH (262)Sento (486)Seplxoi (232)SERBIA (761)SEVEQIS (219)SFNGXXAG (1.031)SGHFUVE (1.282)ShaaoTng (1.180)Shanrya (219)Sharplace (343)Sheba (229)SHEEGO (664)SHEFENMEBE (473)SHFTQXSLAT (2.380)SHGJGH (1.566)Shirtracer (419)ShuaaM (295)SHUAINAN (1.313)shunvcw (393)SIA Abrasives (455)SIAQWYENZ (957)SICOTTON (1.217)SIDYEUHB (5.837)SIEMENS (5.198)Siena Garden (685)SIGEL (253)Signes Grimalt (225)Sika (228)Silbergift (265)Sileduove (420)Silverline (257)SIMPLETEK (213)SiSinkal (386)Siunwdiy (256)Sizzix (219)SJHFKDK (401)SJJBVPYX (234)SJQKA (225)SJSJJAH (492)SKECHERS (314)SKF (1.169)SLV (793)SLXWSXZE (1.891)Smatano (2.223)SMEG (250)SMZhomeone (470)snowchecking (688)SNQ (935)SO-TECH (860)SO-TECH® (614)Songmics (246)Sony (496)SOS ACCESSOIRE (246)SOTECH (251)Sourcing Map (1.160)SOYACONCEPT (215)Spacnana (234)sparefixd (265)Spax (272)Spear & Jackson (309)Spelsberg (436)SpoonflowerHome (209)SPORTARC (735)SPPW (1.425)Spreadshirt (334)Springwillfly (271)Sqnbra (2.617)SQOFHA (877)SQSKSSWOB (721)SRQORT (690)SSDZVTRE (936)SSOPTMCB (1.453)Stabilo (239)Staedtler (364)Stahl-Shop24 (434)STAHLWERK (286)STAHLWILLE (1.187)Stallmann Design (559)Stanley (899)Star Cutouts (438)Starrett (236)Starrypxl (661)StarTech (559)Star Trading (279)STEIGNER (365)Stelton (338)Stier (374)Stiga (225)Stihl (743)Sting (202)stoneandstyle (213)Storage Bag (311)STREET ONE (1.357)Street One Studio (244)Striebel & John (703)STRJUS (420)STSTS (428)SUAGFW (226)Suinga (219)Sumsoctober (874)SUPVOX (223)SUTVCM (313)SW-Stahl (438)SWG (291)SWRVVMJDTN (996)SWZEC (602)Sxhlseller (640)SXJY (326)SYBNIKOLF (341)SYLALE (304)SynapSYA (221)SZBTQMUW (834)SZLXJMFL (555)SZRDBHAUJO (416)Szwaldaper (1.449)Sägeband-Manufaktur (350)TT-ProTek (29.310)TAFASVCVMK (355)TAPAUVCK (1.327)Targus (222)Tarifold (241)Tbest (285)TBHEEPQQ (1.600)Tbrov (810)TCYNNQVD (1.834)TECE (287)TE CONNECTIVITY (248)tecuro (387)TECWERK (741)TEFAL (225)Telegärtner (259)TellusRem (327)Temhyu (522)TEMOOUES (207)TENYELE (359)Tesa (583)TEUTO BILDERRAHMEN (403)texxor (1.405)TGDGFKIAS (389)The Living Store (483)Thermaltake (206)Thermos (344)THERMO TECH (247)THINCAN (469)Thun (248)ThyssenKrupp (260)Tidevib (412)TIEOAXFT (287)TIGREZY (324)tilldekor (615)TINGYUS (355)tktrading24 (257)Tlily (1.071)TMK ArtDeko (380)TNBCCXN (238)TNFMJSRXE (1.240)TNGYTY (653)TNTGEBFVBG (244)TNTVLMVUZ (4.844)TOMMY HILFIGER (297)TOM TAILOR (471)TONIXY (409)Toolcraft (11.537)ToolNerds (304)TOOLNOX (1.610)ToolsEvery (392)Toom (259)Topiky (225)Top Industrieteile (340)Tork (346)TOYANDONA (257)Toyvian (279)Tp-Link (391)TPIONEER (322)TQHSAG (293)TracoPower (837)Trade-Shop (1.119)Trade Shop (326)TrAdE shop Traesio (4.381)Transcend (343)Trend (369)Tre Ponti (262)TRFBD (484)TRFVDVERD (574)TRIGEMA (343)Trilux (256)TRIO (256)TristarColor (3.369)Trixie (1.355)TRU Components (472)Trust (212)TRW (271)TRWUQHGD (816)Träumeland (557)Tsinesla (730)Tupperware (632)Turmfalke Sägen&Messer (499)Twinkys (288)Twixral (4.290)TXJZUQPJ (4.624)TXLDZSWO (526)TXLEAPEY (202)TYBOPHQJ (227)TYGIYY (474)TYNBV (1.223)Tyuhren (531)Türck (1.899)UU/R (2.010)U24 (1.161)UAGFDFF (722)UDAMX (247)UGREAT (202)UGUGU (497)UGZPWQLNX (519)UHHIKSRA (2.884)uHLANQC (1.622)UIHMSWYAL (1.156)Ujjdwiurgh (673)UKWYMIDKS (658)ULISEM (661)ULPTOBKUD (440)Ultradex (280)UMIXIRE (243)Unbekannt (1.109)UncleS (494)Under Armour (215)UNTERING (776)UOSIA (658)Up Country (245)UPKOCH (230)UPQQBZFZD (690)Uqezagpa (389)URAGER (3.415)Urban Classics (289)UrbanHui (278)URPIZY (426)URTYP (529)UTONGMU (488)UTTASU (929)Uvex (634)uvmgmync (210)UYUUBNK (2.113)VV-TAC (550)Vaillant (335)VARNOK (2.613)VAYEODEYU (298)Vbbrswaad (412)VBESTLIFE (562)Vdaxvme (224)VDB (307)VDCVADKYE (512)VELILLA (485)Venti (396)Verbatim (207)Vero Moda (330)Versa (222)Vertbaudet (226)Vervaco (262)VEVOR (777)Vexilon (522)VFEBTSD (222)vhbw (10.571)VHEOKG (542)VICASKY (302)Vicco (614)vidaXL (14.810)Viega (763)VIEPGJ (205)Vigor (746)Viking Signs (1.314)Viking Tech (1.168)Vikye (426)Vilgftyiet (520)Villeroy & Boch (1.324)VintageandGlory (264)Violiica (482)Virutex (336)Visiodirect (4.083)VITAdisplays (241)VIVANCE (696)Vjsujehgy (473)VLALAMNO (994)VNRQJLSN (1.886)VO design (308)Volakebeing (611)Voltcraft (316)VoltShine (282)VOLURE (277)VOSERY (1.667)VOSSEN (421)VPCPWTYZY (619)VPLPEREQAK (1.770)VPNMNZTPAP (2.363)VRTYVEYBB (725)VSafety (1.096)VSNPJPVPH (749)Vtizikl (231)VTMTZVLVAD (404)VTSGBLS (372)Vuzmode (817)Vvhabpm (510)VÖLKEL (1.323)WWAGO (1.025)Waigg Kii (248)WAJUHJK (5.455)Waldhausen (342)Walfront (327)Walkiddy (446)Wallario (2.900)walther design (562)WandStyle (260)Warnick´s Tierfutterservice (209)wash+dry (229)Watreketal (939)WAVATA (221)WAVESHARE (532)WAWPU (366)WBCDXCBB (1.641)Wdbild (586)Webana (227)Weicon (506)Weidmüller (5.424)Weischer (278)WEITINGKKK (663)Weixxoai (2.304)WELDRIC (877)Weller (351)Wenko (1.113)wenyouya (731)Wera (575)WESTCH (6.095)Westmark (309)Wexxaii (678)WheatThrive (415)Whiskas (243)Whistler (220)WHOPBXGAD (262)WHRLQXM (779)Whychstore (314)Wiha (702)WIIYENA (250)WILLOW TREE (206)Wiltec (295)WINCHKING (251)Winshape (273)Winsor & Newton (265)WIRTH (235)Wiska (486)WITTYL (6.081)Wivplex (761)WJZJSVWTAU (4.725)WKXTECZT (1.008)WLWOZMD (614)WMF (609)Wolf (260)Wolfcraft (359)Wolters (353)Wolters Cat & Dog (247)Wouapy (317)WSBOJXTH (663)WSQHAO (320)WSUMKH (2.567)Wulkow (370)WUSHADEHANS (225)WUUKEPSG (3.672)WUYJCVHK (266)WVPJJNXAFN (1.600)WXEXUDIN (822)WXVFX (1.889)WYQXTY (860)WÄSCHEPUR (631)XXAGMODSHN (264)Xanorrg (808)XaoLaoC (697)XDDQWSWA (299)XDXLBGDGAN (423)XEBRAD (514)XEDLAMP (748)XEINNILL (635)Xerox (251)XFMZFUBD (234)XGINERFEX (3.112)Xgupxuc (610)XGUZRVGNV (807)XHFTFNLTI (1.595)XIAOBINGFA (279)XIAOCE (3.411)XIAOFEIDAFA (478)XIAOGYYE (2.600)XIAOPANG (1.376)XIEMINLE (537)XINSHILING (2.217)Xiuganpo (754)XJQHK (264)XTINKOPW (1.712)XTSQUHPNH (5.184)XTVVTODJXT (2.243)XUEJS (311)XUPBEHJO (466)XURO (348)XUWSXA (540)XUXINYCS (551)XVX (841)XWMGOQNZ (533)XXHNBF (589)XYAGYUND (1.019)XYVXGGRM (5.617)XZGFZHY (5.681)YYanmis (419)YATINGZHANG (210)Yato (280)YBAAKZIIR (470)Yctze (499)YDCDFVBVGM (603)YDHSIKK (205)YENDOSTEEN (1.861)Yeti (318)YEUBXDJ (419)YGoal (313)Yhenlovtt (288)YHFZR (2.135)YHNNH (7.707)YINLUCK (256)YIRONCNPA (930)YIZITU (616)YJQHODY (2.457)YJXYJQ (453)YKMYXZ (224)YKYNCJJT (237)YLHMG (263)YLPWKMVZ (300)YMDK (502)YMYNY (813)YNKJFOD (346)YobiLife (477)Yonghongzc (233)YOSLQRRCX (753)YOUZKA (415)YOYO (289)YPDOPORA (554)YQRYRYLE (277)YRIIOMO (203)YSASFZX (1.584)YSFDSG (301)YSFIFHSKFH (361)YSPOKJ (212)YSQOJF (793)YTACPN (886)YTBHSHXZ (600)YTRAVHI (411)Yuanpgky (470)YUBAOLI (929)YUERBNC (703)YUEYZHK (302)YUGSHNKFC (541)YuliiaMykhaliukArt (257)YUNNIAN (205)Yunseity (293)Yurefax (225)YUXVBTZXD (865)YUZGUHEY (340)YVAAASIYC (225)YWBL-WH (374)YXFCD (499)YXZKJZJ (1.246)YYGGWL (855)YYJOUPLM (443)YYULZO (958)YZATCDZG (7.312)YZHYWJFF (1.649)YZWRWRMKTB (260)ZZADIKO (563)Zahara (1.320)ZAMETTER (257)Zarivy (475)ZBLNKZNGKA (2.149)ZBORAVPIX (2.808)ZBYFCLK (376)ZCDYGHU (384)ZDDYUU (624)ZDVHOMCB (267)zengxi (378)ZEPFJHE (502)Zerodis (260)zeroupshop (544)zesendz (1.279)ZFISH (555)ZFUWWA (689)ZGCrumphant (278)ZGHQHCDRH (7.339)ZGPOSQKZSC (1.434)ZHAJNG (1.469)Zhaoqian (632)ZHFSWLKW (276)ZHUNTESM (1.056)ZHURDFT (442)ZHUYRT (517)Zialofi (268)ZIENER (320)Zilimontt (681)ZiStarlilife (314)ZIXMIX (556)ZJchao (228)Zkydhbd (297)ZMdooreasy (280)ZMGYF (699)Zoegneer (210)Zoeyilan (202)ZOOPH (373)Zoternen (347)ZPFPFZ (252)ZPTPNGWH (242)Zqxnt (342)ZRUIORL (463)ZSHYTWE (1.308)ZTOSZSPT (4.214)ZTZHVNVGK (1.706)ZTZTZ (621)Zunate (486)Zuoeay (406)ZVD (1.318)Zwilling (240)Zwillingsherz (224)ZWTPGKRD (572)ZXCDLCCJD (986)ZXZFDC (491)zyimodl (249)ZYinGgY (1.344)ZYLARUM (294)ZYMIADOU (346)ZYNCUE (264)ZYWUOY (362)ZZWFMW (426)Material
Farbe
25-50 €
Preis

ROMISBABA Vogelbrutkasten aus Naturholz mit Außenhängevorrichtung Platzsparend Leicht zu Reinigen Wärmeisoliert für Wellensittiche Nymphensittiche Unzertrennliche und Andere Papageienarten
von ROMISBABA
gefunden bei Amazon
26,49 €

ROMISBABA Faltbare Atmungsaktive Tragetasche für Katzen und Kleine Hunde mit Großem Belüftungsfenster Verschließbarer Seitentasche und Verstellbarem Schultergurt Vielseitige Verschleißfeste
von ROMISBABA
gefunden bei Amazon
26,39 €

ROMISBABA Verstellbare Rasenlüfterschuhe mit Stahlspikes Strapazierfähige Garten Nagelschuhe zum Belüften von Boden und Gras Passend für Schuhe Langlebig und Einfach zu Montieren Schwarz
von ROMISBABA
gefunden bei Amazon
32,69 €

ROMISBABA Erhöhter Keramik Futternapf mit Stabilem Eisenhalter Doppelte Schalen für Katzen und Haustiere Leicht zu Reinigen rutschfest für Trocken und Umweltfreundlich und Hygienisch
von ROMISBABA
gefunden bei Amazon
36,19 €

ROMISBABA Tragbarer Blaubeerpflücker mit Griff Garten und Obstpflückgerät Gartengerät mit Stahlzinken Ergonomisch für Obstgärten und Heimgebrauch Geeignet für Altersgruppen
von ROMISBABA
gefunden bei Amazon
30,69 €

ROMISBABA Verstellbarer Pneumatischer Pulsator mit Zwei Ausgängen aus Edelstahl und Kunststoff für Kühe Ziegen und Schafe Melkzubehör für Landwirtschaftlichen Dauereinsatz
von ROMISBABA
gefunden bei Amazon
30,23 €

ROMISBABA Verdickte wasserdichte Oxford Springbrunnenabdeckung UV Beständig Abnehmbar Vollflächiger Schutz für Outdoor Einfache Handhabung Wetterfester Gartenschutz
von ROMISBABA
gefunden bei Amazon
31,49 €

ROMISBABA Edelstahl Kaffee Grounds Behälter mit Abnehmbarem Knock Bar und Rutschfestem Pad Kaffeesatz Abklopfbehälter für Siebträger Praktische Kaffeebohnen Aufbewahrung für Zuhause
von ROMISBABA
gefunden bei Amazon
25,59 €

ROMISBABA Transparente Große Haustier Tragetasche mit Verstellbaren Gurten Kratzfest und Bequem für Katzen und Hunde für Reisen Camping und Ausflüge im Freien
von ROMISBABA
gefunden bei Amazon
30,99 €

ROMISBABA Edelstahl Ölkanne Auslaufsicher Ölbehälter Große Kapazität Ölaufbewahrung für Küche und Restaurant Modern Poliert Praktisch Vielseitig
von ROMISBABA
gefunden bei Amazon
25,79 €

ROMISBABA Wetterfeste Resin Haustier Grabstein Gedenkstein Statue mit Hundemotiv Langlebig und Kompakt Garten Gedenkfigur für Hunde und Katzen Pflegeleicht und als Erinnerungsgeschenk
von ROMISBABA
gefunden bei Amazon
27,49 €

ROMISBABA Faltbarer Fahrradkorb für Hunde Vorne aus Atmungsaktivem Oxford Abnehmbarer Griff Geräumiger Haustierträger für Kleine Hunde Komfortabler Fahrrad Pet Basket in Modischem
von ROMISBABA
gefunden bei Amazon
30,29 €

ROMISBABA Automatische Vogel Badewanne mit Zirkulierendem Wasserduscheffekt Wassersparendes Vogelbad für Kleine Haustiere Indoor Badewanne mit Natürlichem Regendusche Erlebnis
von ROMISBABA
gefunden bei Amazon
28,19 €

ROMISBABA Keramik Ölkanne Hohe Temperaturbeständigkeit Große Kapazität Retro Design Vielseitig für Speiseöl Schweineschmalz Vorratsbehälter Küche Robust und Leicht zu Reinigen
von ROMISBABA
gefunden bei Amazon
27,33 €

ROMISBABA Gel Kühlmatte für Haustiere Wiederverwendbare Tragbare Kühlmatte mit Gelkissen Waschbar Leicht Sichere Kühlung für Katzen und Hunde im Sommer für Reisen und Outdoor
von ROMISBABA
gefunden bei Amazon
28,69 €

ROMISBABA Verstellbarer Universeller Reifenwechsel Schlüssel mit Stecknüssen aus Langlebigem Material Teleskopisch Kompakt für Auto Reparaturen und Einfache Handhabung
von ROMISBABA
gefunden bei Amazon
29,59 €

ROMISBABA 3 Stück Teiliges Edelstahl Schuhdisplay Rostfrei Poliert Stilvoll und Robust für Schaufenster und Schuhpräsentation im Einkaufszentrum Leicht und Einfach zu Handhaben
von ROMISBABA
gefunden bei Amazon
30,49 €

ROMISBABA 2 Stück Erhöhte Keramik Katzenfutterschale mit Nackenschutz Rutschfester Katzennapf für Bequemes Fressen und Trinken Spülmaschinenfest Großes Fassungsvermögen Modernes Design
von ROMISBABA
gefunden bei Amazon
25,99 €

ROMISBABA 100 Stück Tropfbewässerung Endkappen Tropfband Abschlussstopfen aus Langlebigem Installieren Robust und Wetterbeständig für Garten und Landschaftsbewässerungssysteme
von ROMISBABA
gefunden bei Amazon
27,49 €

ROMISBABA Automatischer Keramik Trinkbrunnen für Haustiere Tragbarer USB Wasserspender mit Zirkulierendem Wasser Kleiner Bunter Pilzbrunnen für Katzen und Hunde Praktischer Wasserautomat
von ROMISBABA
gefunden bei Amazon
34,69 €

ROMISBABA Kompakter Eleganter Fußhocker mit Holzbeinen Gepolstertem Sitz Vielseitig als Meditations und Fußstütze Platzsparend für Wohnzimmer Schlafzimmer Büro Geeignet
von ROMISBABA
gefunden bei Amazon
32,09 €

ROMISBABA Höhenverstellbarer Faltbarer Kleiderbügel mit Integriertem Bügelbrett Stabiler Vierbeiniger Dampfbügler Ständer Geeignet für Handdampfglätter und Dampfbügelstationen Praktische
von ROMISBABA
gefunden bei Amazon
32,89 €

ROMISBABA Großer Vogelkäfig mit Vintage Design Tragbarer Kunststoff Vogelkäfig für Wellensittiche Nymphensittiche und Perlvögel Komfortables Zuhause für Innen und Außeneinsatz Einfach zu
von ROMISBABA
gefunden bei Amazon
33,09 €

ROMISBABA Automatischer Infrarot-induktions Futterspender Für Haustiere Mit Großem Fassungsvermögen Und Rutschfestem Boden Geeignet Für Katzen Und Hunde
von ROMISBABA
gefunden bei Amazon
49,69 €

ROMISBABA Verstellbarer Grillkorb Drehbar für Fisch Hähnchen Gemüse Ausziehbarer Bbq Grillkäfig für Gleichmäßiges Grillen Beim Camping und Familien Outdoor Events
von ROMISBABA
gefunden bei Amazon
25,39 €

ROMISBABA Spawning Cage Bienenkönigin Käfig Imkereizubehör Langlebig Sicher Praktisch zur Bienenzucht Geeignet für Imker Einfache Handhabung Bienenschonend
von ROMISBABA
gefunden bei Amazon
28,39 €

ROMISBABA Hamster Laufrad mit Stabilem Metallrahmen Geräuscharm für Hamster Mäuse Meerschweinchen und Igel Rutschfestes Langlebiges für Käfig und Kleintierhaltung Dunkelgrün mit Goldenem
von ROMISBABA
gefunden bei Amazon
25,09 €

ROMISBABA Hölzerne Langlebige Haustier hängebrücke mit Versteck für Kleine Tiere Wie Chinchillas Hamster Meerschweinchen und Ratten Platzsparend Leicht und Einfach im Käfig zu Montieren als
von ROMISBABA
gefunden bei Amazon
27,59 €

ROMISBABA 2 STÜCK Handgefertigtes Gras Kaninchenhaus Kleintierversteck aus Robustem Geflochtenem Naturmaterial Faltbares Nest für Meerschweinchen und Kaninchen Gemütliche
von ROMISBABA
gefunden bei Amazon
26,09 €

ROMISBABA Edelstahl Rührpaddel für Große Chargen Langlebiges Koch Braupaddel mit Langem Griff Ergonomisch für Meeresfrüchte Gärung und Bierbrauen Rostfrei und Leicht zu Handhaben
von ROMISBABA
gefunden bei Amazon
25,69 €
ROMISBABA 20 Stck Teiliges Vorgefüllt für Wissenschaftliche Experimente Kleine Petrischalen für Mikrobielle Kultivierung Tragbare Nährböden für Labor und Schule
von ROMISBABA
gefunden bei Amazon
25,19 €

ROMISBABA Fach Automobil schaltpanel mit Dual USB Ladebuchsen Digitalem Voltmeter Zigarettenanzünderhalter für Auto Yacht Lkw Wohnmobil Vielseitiges Kontrollpanel mit Kippschaltern und
von ROMISBABA
gefunden bei Amazon
35,67 €

ROMISBABA Faltbarer Katzentunnel als Katzenbett für Drinnen Geräumiger Spiel und Schlafplatz Strapazierfähiges Stoffmaterial Leicht zu Reinigen Fördert Interaktives Spiel und Haustierbindung
von ROMISBABA
gefunden bei Amazon
27,29 €

ROMISBABA Intelligenter Schneller Kühl und Heizbecher mit Digitalem Display Temperaturregelung Praktische Getränkekühlung und Wärmeerhaltung Geeignet für Büro Zuhause und Auto Weiß
von ROMISBABA
gefunden bei Amazon
47,39 €

ROMISBABA Reptilien Fütterungsbox mit Belüftung Transparente Kleine Zuchtbox für Spinnen und Echsen Langlebiges Gehege mit Magnetischer Schiebedichtung für Einfache Pflege und Sichere
von ROMISBABA
gefunden bei Amazon
34,59 €

ROMISBABA Nachbildung mit Detaillierter Zahnstruktur für Studenten und Techniker Langlebiges Übungsmodell für Zahnarzt-ausbildung und Praxis
von ROMISBABA
gefunden bei Amazon
25,99 €

ROMISBABA Gusseisen Holzkohleofen Bbq Grillofen Langlebig Robust für Tee und Grillzubereitung für Outdoor Camping und Picknick
von ROMISBABA
gefunden bei Amazon
26,39 €

ROMISBABA Display Sockel für Fischglas Höhe Langlebiger Holzsockel mit Feiner Tragbarer und Leichter Holzfuß für Antike Wohnraumdekoration
von ROMISBABA
gefunden bei Amazon
30,19 €

ROMISBABA Tragbarer Mini Campingkocher Faltbar aus Edelstahl Winddichter Gaskocher mit Spritzschutz Energiesparend und Leicht für Outdoor Wandern Picknick und Bergsteigen
von ROMISBABA
gefunden bei Amazon
26,09 €

ROMISBABA Duschkopf mit Filter Hochdruck Wasserenthärter Rundkopf für Hartes Wasser Chlorentfernung Silberfilter Abnehmbar für Haut und Haare
von ROMISBABA
gefunden bei Amazon
28,09 €

ROMISBABA 3 Stück Mikrolandschaft Glasflasche mit Korken Runde Transparente Terrarium Flasche Versiegeltes Gefäß für Mooslandschaften Dekoratives Home Supplies Accessoire
von ROMISBABA
gefunden bei Amazon
25,69 €

ROMISBABA Toilettenhocker aus Robustem PVC rutschfest für Senioren Toilettenfußstütze Ergonomisch Erhöht für Bequemes Sitzen Zuhause Badezimmerhilfe
von ROMISBABA
gefunden bei Amazon
25,65 €

ROMISBABA Silent Cat Running Wheel Mat Kratzmatte rutschfest Strapazierfähig für Katzen Laufrad Fitnesspad für Wohnungskatzen und Kleintiere Wie Eichhörnchen Igel Geeignet
von ROMISBABA
gefunden bei Amazon
29,69 €

ROMISBABA Sommer Pet Cooling Matte Waschbare rutschfeste Kühlmatte mit Gel Zitronenmuster Komfortable Kühlkissen für Hunde und Katzen Hitzeschutz für Hundekörbe und Böden
von ROMISBABA
gefunden bei Amazon
31,99 €

ROMISBABA Keramisches Hamsterhaus für Chinchillas Kühles Hamsterversteck Spielplatz für Kleine Haustiere Nest für Sommer und Winterruhe
von ROMISBABA
gefunden bei Amazon
29,79 €

ROMISBABA 12 Stück Teiliges Hamstergehege aus Leichtem Eisen Faltbarer Kleintier Auslauf Platzsparend Einfache Installation für Hasen Hamster und Kleine Haustiere Praktisch für Drinnen und
von ROMISBABA
gefunden bei Amazon
27,49 €

ROMISBABA Wetterfestes Resin Vogelhaus Aufhängen Stabiles Garten Vogelhaus aus Robustem Harz Dekoratives Nest für Kleine Vögel Garten Langlebiges Vogelhäuschen für Außendekor
von ROMISBABA
gefunden bei Amazon
27,39 €

ROMISBABA 4 Stück Doppelter Aufhänger für Haustür Kratzfreie Türhaken Passend für Verschiedene Türstärken Eleganter Stil für Weihnachts Festtagsdekoration
von ROMISBABA
gefunden bei Amazon
25,49 €

ROMISBABA Nucleus -modell Zellmodellbausatz Tierisches Zellmodell Zellstrukturmodell Pflanzenzellmodell Mikrobiologisches Modell Zellkernmodell Bildungsspielzeug Lehrmodell
von ROMISBABA
gefunden bei Amazon
31,79 €

ROMISBABA Scratch Pad Für Hunde Kratzbrett Nagelpflege Langlebige Krallenfeile Für Haustiere Effektive Pflege Hundekrallen Geeignet Für Verschiedene Hunderassen
von ROMISBABA
gefunden bei Amazon
29,89 €

ROMISBABA 2 Stück Teiliges Edelstahl mit Segmenten Wetterfester Drehbarer Outdoor fahnenhalter für Haus Garten und Events Rostfrei Stabil und Langlebig
von ROMISBABA
gefunden bei Amazon
30,07 €

ROMISBABA Manueller Wurstfüller Hand Sausage Stuffer Profi Wurstfüllmaschine Küchenhelfer Ergonomisch Einfach zu Bedienen Langlebig Bpa frei für Sauberes und Kraftsparendes Wursten
von ROMISBABA
gefunden bei Amazon
26,39 €

ROMISBABA Mini Reifendruckprüfer Kabellose Digitale Handluftpumpe Tragbar für Fahrrad Auto Motorrad mit Lcd anzeige Leicht und Kompakt
von ROMISBABA
gefunden bei Amazon
46,36 €

ROMISBABA Schnüffelmatte für Hunde Pet Training Matte aus Langlebigem Sicherem Material Fördert Langsames Fressen und Suchverhalten Leicht für Beschäftigung und Futtermotivation
von ROMISBABA
gefunden bei Amazon
27,39 €

ROMISBABA 2 Stück Keramik Katzennapf Erhöhter Futternapf rutschfest Nackenschutz Schräger Volumen Haustier Futterstation für Katzen und Kleine Hunde
von ROMISBABA
gefunden bei Amazon
26,29 €

ROMISBABA Verstellbarer Faltbarer Dampfbügeleisen Ständer mit Stabilem Vierfuß Design Unabhängiger Kleiderhalter Platzsparend Höhenverstellbar für Dampfbügelgeräte und Hemden
von ROMISBABA
gefunden bei Amazon
37,59 €

ROMISBABA Milchflasche mit Weichem Sauger Tragbarer Ziegen und Schaf Tränkehalter für Farm und Zoo Langlebiger Tiermilchspender zur Effizienten Gruppenfütterung
von ROMISBABA
gefunden bei Amazon
30,19 €

ROMISBABA Katzen Gedenkstein aus Langlebigem Harz Kleines Dekoratives Grabstein Ornament für Garten Stabiles Haustier Memorial für Draußen Niedliche Katzendeko als Grabstein Aufsteller
von ROMISBABA
gefunden bei Amazon
30,19 €

ROMISBABA Fahrradkorb aus Umweltfreundlichem Rattan Abnehmbar Stabiler Weidengeflechtkorb für Katzen und Hunde Großer Einkaufskorb Vorne Einfach Montierbar Honigfarben Zufällige Farbe
von ROMISBABA
gefunden bei Amazon
33,39 €

ROMISBABA Robuster Outdoor Müllsackhalter aus Metall Stabiler Gartensackhalter für Laub und Abfall Vielseitiger Abfallbeutelständer für Garten Camping Ernte und Rasenpflege
von ROMISBABA
gefunden bei Amazon
42,79 €

ROMISBABA Schuhregal Kunststoff Stapelbar Multi Funktion Schuhständer Platzsparend Kompakt Für Flur Schlafzimmer Weiß Mehrschichtig Einfach Pflegeleicht
von ROMISBABA
gefunden bei Amazon
28,79 €

ROMISBABA 2stücke Korkrindenplatten Naturbelassen Für Terrarien Und Aquarien Grüne Pflanzenwandpaneel Aus Baumrinde Als Hintergrund Für Reptilien Und Tiere
von ROMISBABA
gefunden bei Amazon
29,19 €

ROMISBABA Gefrierschrank Organizer aus Metall mit Design Fächer Installieren Langlebig für Küche Supermärkte und Restaurants zur Tiefkühltruhe Aufbewahrung
von ROMISBABA
gefunden bei Amazon
27,39 €

ROMISBABA 2 Stück Transparenter Hamster Badebox aus Kleine Sandkiste für Kleintiere Leicht zu Reinigen Staubgeschützt für Chinchillas und Hamster Halbgedeckt
von ROMISBABA
gefunden bei Amazon
25,89 €

ROMISBABA Aluminiumlegierung Fitness pulley Rad Rostfrei Langlebig Geräuscharm für Trainingsgeräte Zuhause Kabelzug Flaschenzug Zubehör
von ROMISBABA
gefunden bei Amazon
25,63 €

ROMISBABA Boot Zündschlüssel mit robustem ABS Metall langlebiges Zündschlossset für Omc Marine Motoren Praktisches Starter Kit mit Schlüsselband Zuverlässige Hauptschalterlösung für Boote
von ROMISBABA
gefunden bei Amazon
25,47 €

ROMISBABA Schwere Weiche Gurtbandrolle Breit Starkes Bindeband für Rucksackriemen Gartenzubehör und Vielseitige Befestigung Schont Pflanzenrinde für
von ROMISBABA
gefunden bei Amazon
25,99 €

ROMISBABA Manuelle aus rostfreiem Metall Tragbares Milchkübel Kühe Ziegen und Schafe Langlebig Hygienisch ohne Strom für Bauernhof und Milchverarbeitung
von ROMISBABA
gefunden bei Amazon
34,49 €

ROMISBABA Verstellbarer Schrankregal Trenner Ausziehbar ohne Bohren Weißer Organizer für Kleiderschrank Küche Bad Platzsparendes Fachsystem für Effiziente Aufbewahrung
von ROMISBABA
gefunden bei Amazon
34,09 €

ROMISBABA Kompakter USB mit Dual-geschwindigkeiten Leise Luftfilter für Schlafzimmer Büro und Kleine Räume Entfernt Rauch Gerüche Allergene für Haustierbesitzer Weiß
von ROMISBABA
gefunden bei Amazon
41,19 €

ROMISBABA Ruhiges Hamsterrad Transparent mit Ständer Laufrad für Kleintiere Wie Mäuse Gerbil Chinchilla Geräuscharmes Übungsrad für Gesundes Haustiertraining
von ROMISBABA
gefunden bei Amazon
33,89 €

ROMISBABA Großes Hundeklo aus Stabilem Material mit Niedrigem rutschfest und Langlebig Praktische Indoor Trainingstoilette für Welpen und Kleine Hunde Leicht zu Reinigen und Formbeständig
von ROMISBABA
gefunden bei Amazon
30,99 €

ROMISBABA Wasserdichter Teilig Atc Sicherungsblock mit Batterieanschluss Hitzebeständig Schutz für Auto Kfz Sicherungsverteiler Einfacher Einbau
von ROMISBABA
gefunden bei Amazon
34,79 €

ROMISBABA 100 Stück Metallkabelplomben mit Nummerierung Wetterfeste Sicherheitsplomben für Lkw Container Temperaturbeständige Manipulationssichere Stahlkabel Siegel zur Sendungsverfolgung
von ROMISBABA
gefunden bei Amazon
33,69 €

ROMISBABA Edelstahl Frittiertopf mit Hitzebeständigem Griff Tiefer Haushalt Fritteusentopf mit Abnehmbarem Frittierkorb Kompakt und Langlebig für Küche Restaurant und Induktionsherde
von ROMISBABA
gefunden bei Amazon
27,09 €

ROMISBABA Federbelastete Torrolle mit Stoßdämpfer Schwerlast gate Caster Tragkraft Wetterfest für Gartentore und Unebene Böden Einfache Montage Langlebiges Material
von ROMISBABA
gefunden bei Amazon
28,69 €

ROMISBABA Fahnenmasthalterung Mit Saugnapf Für Auto Wohnmobil Und Boot Montagehalterungen Aus Aluminiumlegierung Einfache Installation Ohne Bohren
von ROMISBABA
gefunden bei Amazon
31,59 €

ROMISBABA Manuelle Fruchtpresse Handentsafter aus Robustem Material Saftspender für Orangen Zitronen und Andere Zitrusfrüchte Einfache Bedienung Sicher und Langlebig für Hausgebrauch
von ROMISBABA
gefunden bei Amazon
34,34 €

ROMISBABA Aufblasbare Weihnachtskugeln PVC Großes Teilig Grün Vintage Weihnachtsdeko für Garten und Außenbereich Festliche Weihnachtsornamente Zufällige Farbe
von ROMISBABA
gefunden bei Amazon
27,89 €

ROMISBABA Professioneller Imkeranzug Weiß XXL mit Ganzkörperschutz Elastischen Bündchen und Abnehmbarem Schleier für Umfassenden Bienenschutz
von ROMISBABA
gefunden bei Amazon
39,99 €

ROMISBABA Multifunktionaler Rollwagen mit Stabiler Aufbewahrungswagen für Küche Bad Büro und Schlafzimmer Weißer Mobiler Trolley mit Großer Kapazität und Leisen Platzsparendes Lagerregal
von ROMISBABA
gefunden bei Amazon
29,69 €

ROMISBABA Große Kaninchentoilette aus Langlebigem Material mit Auslaufsicherem Design und Abgerundeten Kanten für Kleine Haustiere Wie Kaninchen Meerschweinchen und Zwergkaninchen im
von ROMISBABA
gefunden bei Amazon
29,89 €

ROMISBABA Katzenbadegehege aus Rostfreiem Kratzfest Verschleißfest Tragbar mit Tragegriff Sicherer Duschkäfig für Katzenpflege und Haustierbad Langlebiger und Praktischer Katzenschutzkorb
von ROMISBABA
gefunden bei Amazon
27,69 €

ROMISBABA Große Ergonomische Getreideschaufel mit Siebfunktion Robuste Gartenschaufel aus Langlebigem für Mais Bodenfiltration und Gartenarbeit Leicht und Vielseitig Einsetzbar
von ROMISBABA
gefunden bei Amazon
26,09 €

ROMISBABA 7 Stück Vogelkäfig Zubehör Teiliges Naturholz Sitzstangen mit Rutschfester Oberfläche und Zusätzlicher Plattform Geeignet für Wellensittiche Papageien Kanarienvögel und Kleine
von ROMISBABA
gefunden bei Amazon
25,79 €

ROMISBABA Honigfilter Doppelsieb aus Edelstahl Präzises Mesh Design für Saubere Honig Sirupfiltration Langlebig Einfach zu Reinigen Amerikanisches Design für Vielseitige Küchenanwendung
von ROMISBABA
gefunden bei Amazon
27,49 €